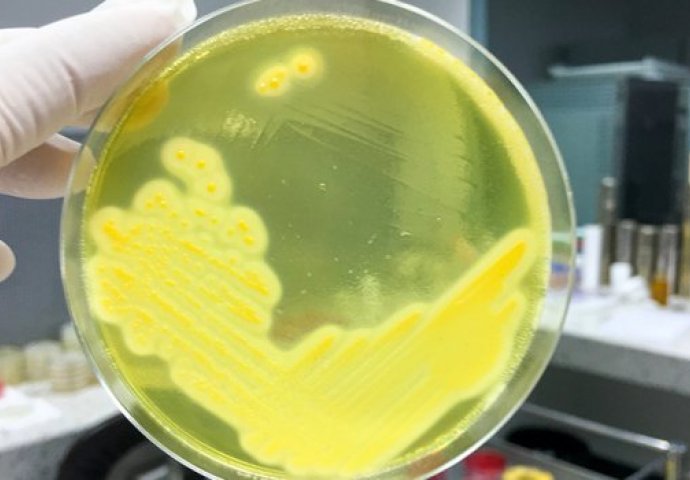

JE LI OVO NAŠ KRAJ? SUPERBAKTERIJA otporna na ANTIBIOTIKE hara bolnicama! Doktori se hvataju za glavu! Ovo ne sluti na dobro!
Velika studija uglednog britanskog instituta Sanger upozorava na superbakterije otporne na antibiotike koje se šire europskim bolnicama, prenosi BBC.

Znanstvenici širenje opasne bakterije Klebsiella pneumoniae nazivaju “iznimno zabrinjavajućim” te upozoravaju kako bi i druge bakterije mogle postati otporne na lijekove – zbog načina na koji se reproduciraju. Klebsiella pneumoniae može živjeti u crijevima zdravih ljudi ne uzrokujući nikakve probleme. No, pri prvim znakovima nekih bolesti i slabosti organizma, širi se te izaziva upalu pluća. Može izazvati i krvarenje, rane na koži, ali i oštećenja na mozgu tj. meningitis. Neki od sojeva te bakterije razvijaju otpornost na antibiotike.

- Ono što posebno zabrinjava jest to što su ove bakterije otporne na suvremene, jake antibiotike koji su posljednja crta obrane”, ističe dr. Sophia David iz instituta Sanger. “Infekcije ovom bakterijom povezane su s visokom stopom smrtnosti - upozorava dr. David te dodaje kako je 2015. godine zabilježeno 2000 smrtnih slučajeva, ali liječnike zabrinjava to što je to možda tek početak, tj. samo najava puno gore, crne bilance koja će uslijediti ako se nešto ne poduzme.

Naime, 2007. u Europi je zabilježen 341 slučaj povezan s ovom superbakterijom, a osam godina poslije ta je brojka narasla na 2094. U ovoj su znanstvenoj studiji, najvećoj do sada o otpornosti Klebsiellae pneumoniae na antibiotike, sudjelovale čak 244 bolnice od Irske do Izraela. Liječnici su analizirali bakterijin DNK, odnosno njezin genetski kod, uzet od inficiranih pacijenata.

- Rezultati naših istraživanja ukazuju na to da su bolnice ključna mjesta zaraze ovom bakterijom te sugeriraju kako se ona širi primarno u bolničkim prostorijama - objašnjava dr. David. Ističe da su u mnogim europskim bolnicama našli isti, visokorizični soj ove bakterije. Znanstvenici također upozoravaju da bi se K. pneumoniae mogla nastaviti širiti, ali i prenijeti svoju otpornost na druge bakterije. Naime, dvije bakterije mogu se spojiti i međusobnim seksualnim odnosom (koji se naziva konjugacija) prenijeti ključne genetske informacije plazmidima, malim prstenastim molekulama bakterijske DNK.

Studija otkriva kako je sposobnost K. pneumoniae na otpornost prema djelovanju suvremenih antibioitika zapisana upravo na plazmidima. Oni se brzo šire među bakterijama”, kaže dr. David, a njezin kolega, profesor Hajo Grundmann sa Sveučilišta u Freiburgu, smatra kako se infekcije ipak mogu zaustaviti. “Higijena u bolnicama, ali i rano otkrivanje zaraženih pacijenata te njihova izolacija, recept su ne samo za usporavanje širenja ovih patogena, nego i za njihovu uspješnu kontrolu”, poručuje on.
Izvor: hayat.ba